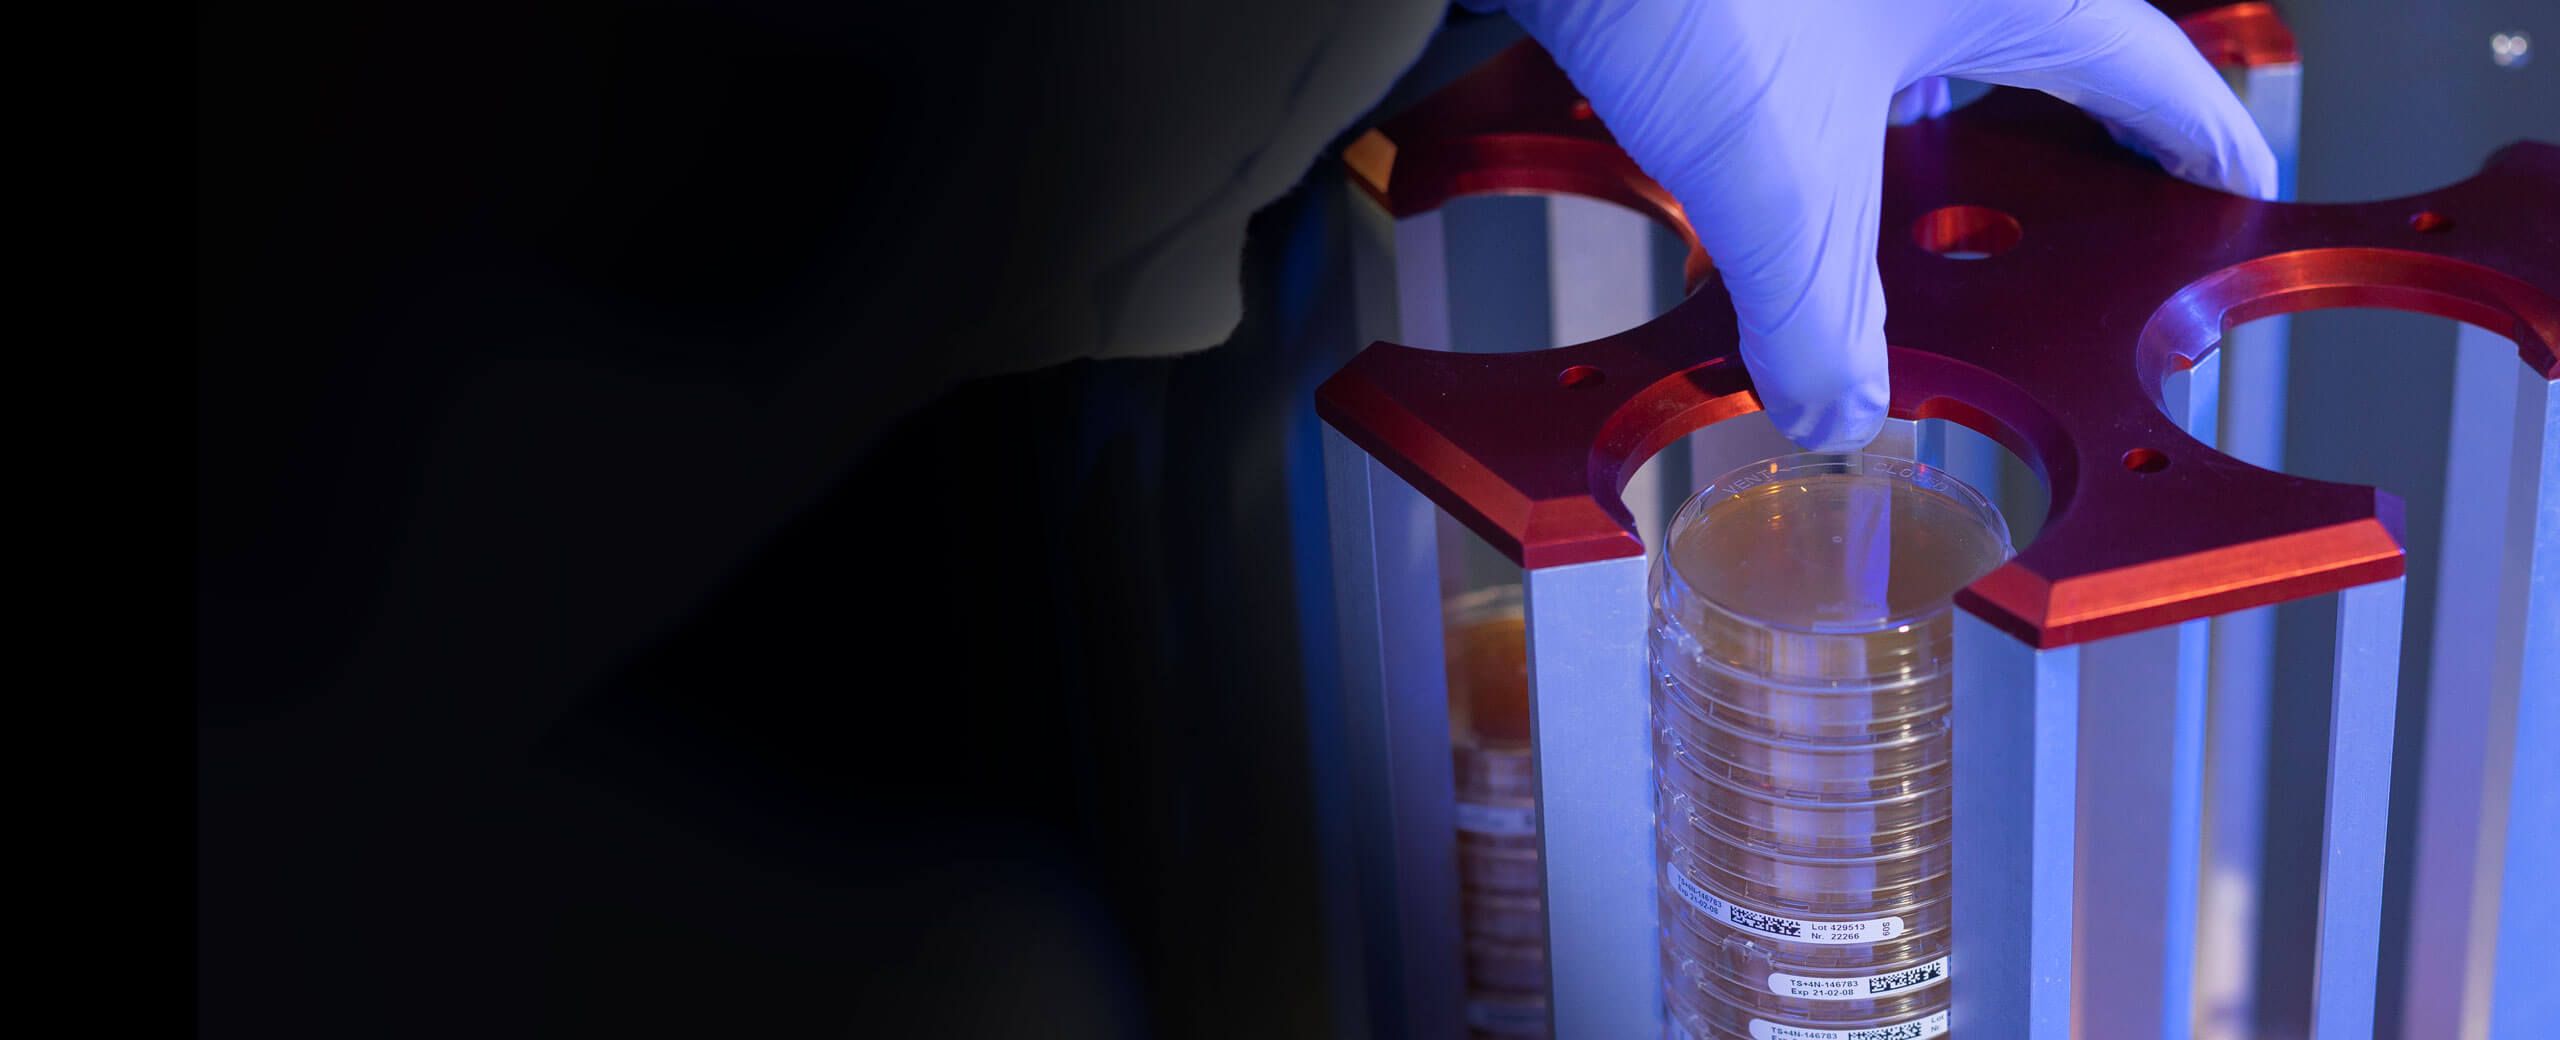

Validation
Validation of the bacSpot Colony Counter System
Your customised solution for fully automated counting of colony-forming microorganisms and plate sorting
- Automated colony counting and plate processing
- High throughput processing of stacked plates
- Automatic plate sorting according to freely selectable threshold
- Integration in LIMS and automatic data management
- Wide range of analysis tools

bacSpot Robot Colony Counter
Ihre maßgeschneiderte Lösung für die vollautomatische Zählung koloniebildender Mikroorganismen und Plattensortierung
- Automatisierte Koloniezählung und Plattenbearbeitung
- Hochdurchsatzverarbeitung von Plattenstapeln
- Automatische Plattensortierung nach frei wählbarem Schwellenwert
- Einbindung in LIMS und automatisches Datenmanagement
- Vielfältige Analysenwerkzeuge
AID bacSpot Robot Systems
Efficiency and Constant Measurements
The automation of colony counting on agar plates will become increasingly important in the future, not only to relieve employees of the demanding visual counting work and to free up capacities for more meaningful occupation. But even to guarantee and ensure constant results and carefree automatic documentation from a regulatory perspective.
Validation
CE
Since 1998 the QM (quality management) of AID has been in accordance with the German Medical Devices Act. AID products bearing the CE mark can be sold anywhere in the EU (European Union) without further validation.
GMP/GLP
The products of Advanced Imaging Devices GmbH (AID reader systems) are designed to work in a GMP/GLP environment under GMP conditions. They can be adapted to individual customer demands at any time to meet the requirements of the strict internal and external guidelines (GMP/GLP).
FDA 21 CFR Part 11
Part 11 of the Code of Federal Regulations defines the criteria by which electronic records and electronic signatures are considered trustworthy, reliable and equivalent to paper records. The software of all AID devices can be adapted to meet these requirements.
DIN EN 62638
We meet the safety requirements for portable electrical equipment, e.g. computers.
DIN EN 61326-2-6
We meet the electromagnetic compatibility requirements for electrical equipment for measurement, control and laboratory use (EMC requirements).
DIN EN ISO (IEC) 62366-1
We use DIN EN ISO 62366-1 to achieve a high level of user-friendliness.
DIN EN ISO 13485 and 21CFR820
ISO 13485 is the harmonised standard for a quality management system for medical device companies. It covers all requirements for medical devices in terms of process control, design control, record keeping, accountability, traceability and more. Advanced Imaging Devices GmbH is certified according to DIN EN ISO 13485. The quality system of Advanced Imaging Devices GmbH also meets the requirements of 21CFR820 (QSR).
DIN EN 62304
We offer software that is an integral part of medical devices or stand-alone software. In order to determine the safety and effectiveness of such software, it is necessary to know what the software is intended for and to prove that the use of the software fulfills these intentions without creating unacceptable risks. For this reason, we adhere to DIN EN ISO 62304 when developing, maintaining and servicing our software.